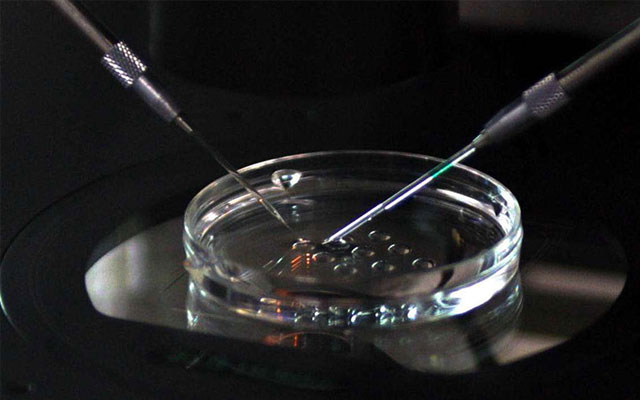
上海大龄供卵试管成功率高么,上海助孕母亲被杀

-
2023-12-31
相关文章精选

试管婴儿移植两个胚胎就一定能生双胎吗?你可能理解错了
2026-01-21

揭秘试管移植双胎全过程!从胚胎培养到成功着床的关键步骤
2026-01-21

想怀双胞胎?试管移植双胎前必须了解的5大医学真相
2026-01-21

高龄女性试管前必做的6项检查,直接影响成功率高低!
2026-01-20

高龄试管成功率提升秘籍!5大科学策略让希望不再遥远
2026-01-20

高龄试管成功率受哪些因素影响?从卵子质量到子宫环境全解析
2026-01-20

高龄试管必避坑!这5个错误操作正在悄悄拉低你的成功率
2026-01-20

高龄试管总失败?子宫内膜容受性差竟是影响成功率的隐形杀手
2026-01-20

试管降调针多少钱一针?2026最新价格表及医保报销政策解析
2026-01-19

试管婴儿降调针费用知多少?五大关键因素帮你精准预估
2026-01-19